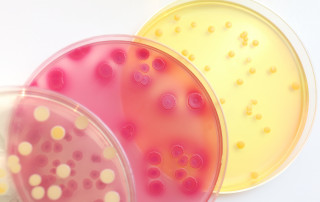

Enamine PL: Międzynarodowy ośrodek badań kontraktowych w Wrocławskim Parku Technologicznym
Jak w zaledwie dwa lata od powstania polski oddzi [...]
Edu4Kids – jak nauka przez zabawę zmienia edukację dzieci?
Początki działalności i inspiracja do stworzenia [...]
Globalny lider we Wrocławiu, czyli o firmie Nokia
Historia firmy Nokia sięga aż XIX wieku, kiedy to [...]
Know-how sposobem na sukces w biznesie, czyli o AMU Automatemeup.com
AutomateMeUp sp. z o.o. to innowacyjny start-up m [...]
Gry z Wrocławia na światowych salonach, czyli o działalności Madnetic Games
Madnetic Games to wrocławski startup z branży gam [...]
Wrocławscy studenci z kosmicznymi ambicjami i międzynarodowymi sukcesami
Studenci z Politechniki Wrocławskiej, dokładniej [...]
Miejska architektura, futurystyczne pomysły i praktyczne prototypy
Czy wiecie, że w przestrzeni warsztatowo-koncepcy [...]
Pure Biologics – jak naukę przekuć w międzynarodowy biznes rodem z Wrocławia?
Pure Biologics jest firmą biofarmaceutyczną skonc [...]
Saule Technologies – sukces z Wrocławia, o którym mówi cały świat
Saule Technologies to firma, która dokonuje rewol [...]
Biznes z doświadczeniem, czyli historia firmy Solveno
Firma Solveno Finanse i Księgowość została założo [...]
Polski potencjał w rozwoju innowacyjnej farmaceutyki – historia WPD Pharmaceuticals
WPD Pharmaceuticals to biotechnologiczna spółka z [...]
Dobry plan na biznes – historia Aerogrease
Aerogrease to firma, która wprowadza na rynek ole [...]
Międzynarodowe doświadczenia kluczem do biznesowego sukcesu – historia spółek Exp-Peco Conseil i Triwalor
Firmy Exp-Peco Conseil oraz Triwalor Inżynieria Ś [...]
Yaskawa Polska – światowy lider mechatroniki na polskim rynku
Yaskawa to firma o długich tradycjach. Powstała p [...]
Ekolabos – technologiczna firma na rynku pełnym wyzwań
Ekolabos to laboratorium zajmujące się wykonywani [...]
Innowacje rodzą się z… innowacji – historia MoCap Systems i Oversiz3D
Historia spółki MoCap Systems wiąże się z realiza [...]
Advantic, czyli od skali laboratoryjnej do przemysłowej
Advantic to polska firma działająca w obszarze pr [...]
Innowacje w praktyce, czyli historia QNA Technology
QNA Technology to firma działająca w WPT, która s [...]
Zrozumienie potrzeb klienta to fundament biznesu – case study Motion Systems
Motions System to jedna z ponad 220 firm działają [...]
Techtra – stały dostawca dla CERN
Technology Transfer Agency Techtra Sp. z o.o. poz [...]
Dołącz do nas na
Więcej z WPT